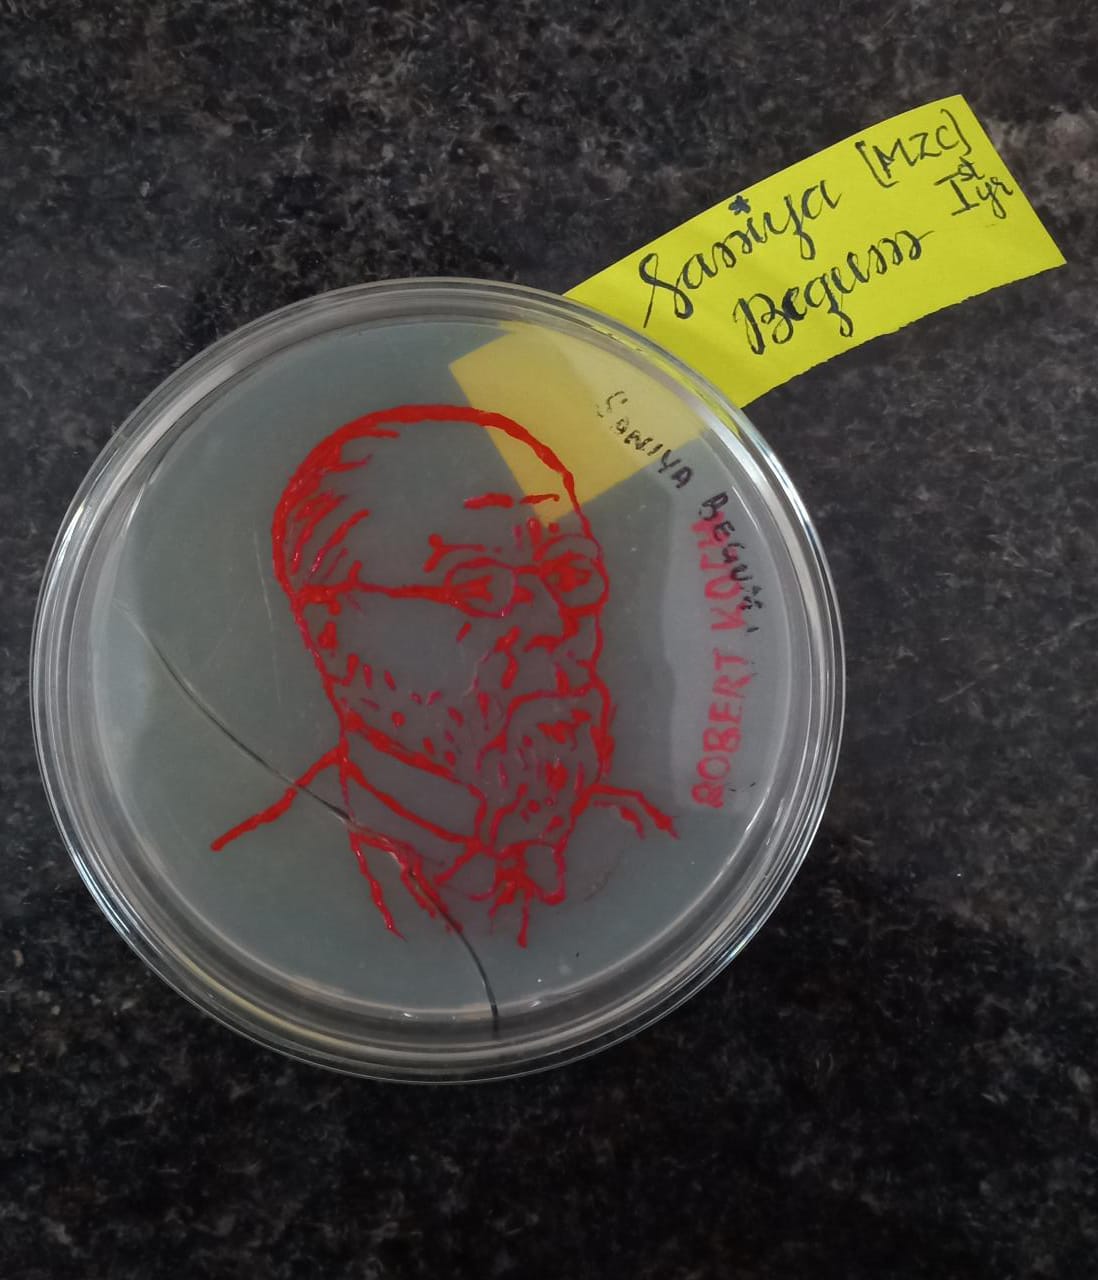

Department of microbiology organized agar-art competition on 16th march 2023 .Agar art is an art work created by culturing microbes in different patterns . Agar art involves planning, coming up with ideas and envisioning the composition and choosing the pattern for art, 30 students participated in the competition.

.jpeg)